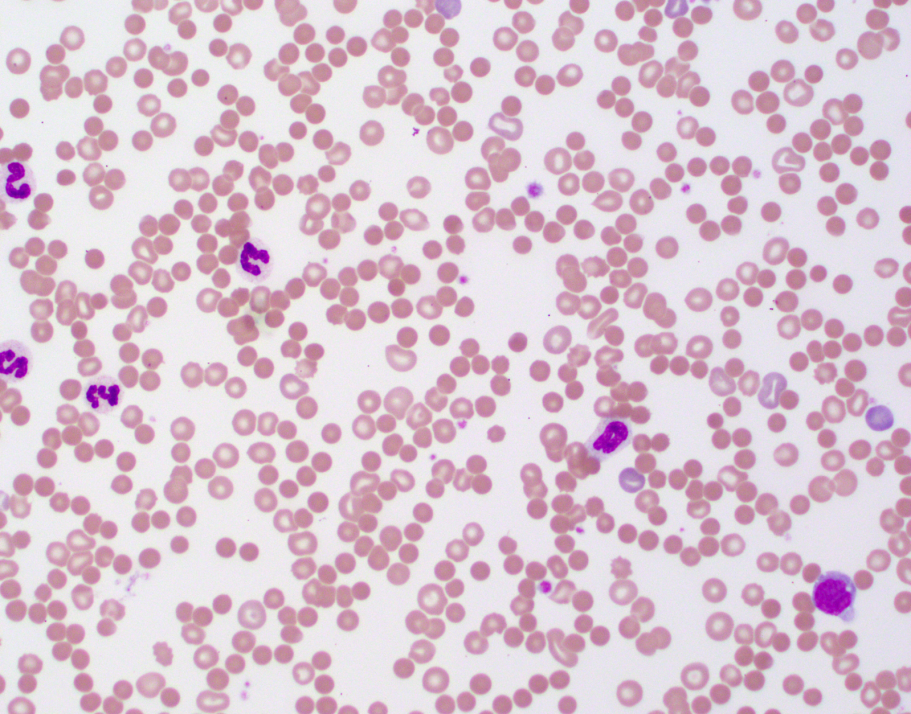

The following information on snakebite in animals is provided for veterinarians:
Snakebite in animals is a common reason for presentation of animals to veterinarians.
Every year in Australia thousands of animals are treated for snakebite and notably many more cases than seen in humans.
Venomous snakes are widely distributed across Australia and the likelihood of interaction with animals is increased during the warmer seasons.
Cats and dogs account for at least 95% of snakebite cases presented to veterinarians whilst only occasional cases occur in horses and other animals.
Snakebite is a particularly seasonal problem with the highest incidence durig the warmer months.
Rural and semi-rural areas have the higher incidence rates of snakebite although outer-urban areas continue to present risk for dogs and cats.
The most important of the venomous snakes found in Australia for animals are brown snakes (Pseudonaja sp), tiger snake (Notechis scutatus) and red-bellied black snake (Pseudechis porphyriacus).
Together these three snake species account have been shown to account for 95% of all snakebites reported in animals.
Brown Snakes (Pseudonaja sp)
The most important members of the brown snake family are the eastern brown (P. textilis), dugite (P. affinis) and western brown snake (P. nuchalis).
Although there are nine different species of brown snake described in Australia there are very few cases attributed to the other members of the Pseudonaja family.
The eastern brown snake is found along the eastern half of Qld, NSW, Vic and SA but not Tasmania. Snakebites in dogs and cats are very common from this species.
The dugite is found in south western West Australia and western SA. The venom is less toxic than that of the eastern brown but still highly lethal. The dugite is found in many populated areas. Snakebite in dogs and cats is common.
The gwardar or western brown snake is found across most of Australia and overlaps in geographical distribution with the eastern brown. It is not found in the eastern parts of NSW and Vic, nor is it found in Tas. The venom yield from milked snakes is typically less than that of the eastern brown and less toxic. Some texts refer to P. nuchalis as the northern brown snake. There is overlap in distribution with other similar brown snakes P. aspidorhyncha and P. mengdeni. However the current taxonomical classification divides these into three separate species rather than as a complex of western brown snakes. Snakebite in dogs and cats from the western brown snake is inadequately described and distinction from the dugite is not possible based on clinical signs.
Other brown snake species include the ringed brown snake (P. modesta) found in the drier parts of all mainlain states except Vic, Ingrams' brown snake (P. ingrami) around the Qld-NT border, speckled brown snake (P. guttata) in central Qld to eastern NT and peninsula brown snake (P. inframacula) found only on the south-west coastal region of SA.
Click here to read more about brown snakes
Tiger Snake (Notechis scutatus)
Tiger snakes are highly dangerous to animals, in the current taxonomic classification there is only a single species defined (Notechis scutatus). Whilst there is significant variation in tiger snake colour and size, these are considered environmental adaptations than sufficient to be classified as separate species. Tiger snakes are found in south-western Australia, Tasmania, Victoria, New South Wales and in certain areas in Queensland. Offshore island populations exist along various southern Australian coastal regions (incl. Roxby & Revesby Islands, King Island, Flinders & Chappell Islands, Rottnest & Garden Islands, and Kangaroo Island).
Click here to read more about tiger snakes
Black Snakes (Pseudechis sp)
The most important member of the black snake family is the red-bellied black snake (P. porphyriacus). In a study of snakebite in animals in New South Wales this snake accounted for 45% of animals presented to veterinary clinics with snakebite. The king brown (P. australis) is not a brown snake rather a member of the black snake family and occasional animal envenomations by this prolific venom producing species have been described.
Click here to read more about black snakes
Copperheads (Austrelaps sp)
The copperhead family of snakes includes three species (lowland, highland & pygmy) which, despite their widespread distribution, only infrequently cause envenomation of animals. Copperheads are a cool-climate snake found in Victoria, Tasmania, parts of NSW and SA. In a study of snakebite in animals in New South Wales, copperheads accounted for 1.6% of animals presented for veterinary treatment.
Click here to read more about copperheads
Taipans (Oxyuranus sp)
Taipans (Oxyuranus sp) highly venomous snakes found in Australia. However, animal envenomations are infrequent but potentially fatal. The Coastal Taipan is found in Northern Australia and bites in animals have been described in Townsville. Taipan bites are rare in animals. Initial clinical signs such as coagulopathy, weakness progressing to neuromuscular paralysis and respiratory failure were described in a dog. Myoglobinuria was observed. Aggressive therapy including mechanical ventilation and specific antivenom are required.
Click here to read more about taipans
Death Adders (Acanthophis sp)
Death adders are an ambush predator and produce a highly neurotoxic venom. Deather adder envenomation in animals is very uncommon. Although a high incidence of death adder envenomation has been described in dogs resident on Magnetic Island, Queensland. The death adders live on or near the coastal rocks and death of dozens of curious dogs has been reported in the media. Occasional cases have been described in dogs in NSW, WA and Qld. The response to specific antivenom appears to be good with rapid reversal of paralysis noted in some cases. Some cases have also been treated with neostigmine and atropine.

Australia is home to numerous species of snakes, many of which relatively little is known about their venom and its potential toxins. The following is a brief summary of various snakes that may potentially be harmful to animals and humans.
Black Whip Snakes (Demansia papuensis, Demansia vestigiata)
The black whip snakes are found throughout northern Australia and their body may be black, olive or light brown in colour. The black whip snakes can reach up to 2 metre in length. A recent veterinary case report described the clinical signs, treatment and outcome in a 9-year-old neutered female Jack Russell terrier following a bite from a Black Whipsnake (Demansia papuensis species group). The bite caused local inflammation and necrosis, progressing to extensive bruising and marginal thrombocytopenia. An SVDK run on blood sample returned negative results in all wells. Clinical signs resolved after treatment with opioid analgesics, broad-spectrum antimicrobial drugs, antihistamines and glucocorticosteroids.
The lethal dose in mice of D. papuensis was found to be > 14 mg/kg, indicating it is of very low lethality relative to the other venomous Australian snakes (many are <0.1 mg/kg). Bites in humans are described as painful and significant swelling at the site can occur.
Yellow-faced Whip Snake (Demansia psammophis)
The yellow-faced whip snake is widely distributed throughout Australia. The snake is recognised by the distinctive black 'comma' shaped skin colouration around the eye. The snake is typically 0.8 m long and distinguished from eastern brown snakes by the facial colouring. The venom has not been studied in great detail but it has sbeen shown to be lethal to guinea pigs. Persistent pain and swelling have been described in humans bitten by this snake. The recommendation for antivenom is to use Tiger-Brown Antivenom as venom from D. psammophis reacts with antibodies made to these venoms.
White Lipped Snake (Drysdalia coronoides)
This small and distinctive snake is found in Tasmania, Victoria and coastal NSW. Maximum length of 50 cm is described but typically these are 20-30 cm in length. A characteristic black stripe and white margin extends below the eye and gives the snakes its name 'white lipped snake'. Relatively little is known about the venom of this snake but significant envenomation has been described in two human cases. Elevated serum CK (<50,000) and myogloburia was described in one person bitten on the skin between thumb and index finger. The patient was administered tiger snake antivenom and made a full recovery within 48 hours.
Anecdotal reports from veterinarians suggest that cats may catch these and become envenomed. No detailed case reports have been described but caution is advised when investigating potentially snakebite in animals from the white lipped snake.
Museum Victoria link to white lipped snake
Molecular studies of the venom have found proteins belonging to eight different snake venom protein superfamilies, namely, three-finger toxins, serine protease inhibitors, cysteine rich secretory proteins, phospholipases A2, venom nerve growth factors, snake venom metalloproteases, vespryns, and a new family phospholipase B.
Bardick (Echiopsis curta)
This snake is found in southern parts of Australia in WA, SA and western Victoria. The venom has had relatively little study but appears to contain no coagulant toxins and mild neurotoxin activity. A confirmed case report in a human subject was found to test positive for death adder venom on the skin with the SVDK. It has been suggested that death adder antivenom may be the most appropriate antivenom in confirmed cases of snakebite.
http://www.toxinology.com/fusebox.cfm?fuseaction=main.snakes.display&id=SN0510
Eastern Small Eyed Snake (Cryptophis nigrescens)
This small snake, typically 50cm long, can be confused with the red bellied black snake (Pseudechis porphyriacus). The snake is found in the eastern regions of Australia from Victoria to Northern Qld. The average venom yield from milked snakes was 5 mg in one study. The venom contains components that have immunological similarity to tiger snake venom and may react in an SVDK to tiger. Tiger-Brown Snake antivenom is recommended for confirmed envenomation by this snake. Experimental studies in dogs revealed that the venom is potentially lethal and initial signs of vomiting and diarrhoea with myopathy. A human death has been recorded in Australia from this snake. Envenomed dogs left untreated or with delayed treatment may experience prolonged (1-3 weeks) illness with myopathy and myoglobinuria.
https://australianmuseum.net.au/learn/animals/reptiles/small-eyed-snake/
Farquharson, K., R. Webster, B. Mackay and T. King (2011). Suspected small-eyed snake (Cryptophis nigrescens) envenomation in a dog. Aust Vet Practitioner 41(3): 117-121.
Curl Snake (Suta suta)
This snake is found largely in central Australia but has widespread distribution. A confirmed death in a cat following a bite from this species is recorded. The mode of action of the venom is neurotoxin related.
Bandy-bandy or Ringed Snake (Vermicella annulata)
The Bandy-bandy is a small snake with characteristics black and white bands evenly spaced along the body. The venom from this snake has not been studied in detail but studies in rabbits suggest it is potentially lethal. Venom effects appear to be neurotoxic. Tiger Snake antivenom is recommended for treatment of envenomation but there is only limited evidence to support its efficacy. In vitro studies of this venom have recently demonstrated neurotoxic activity.
Pycroft, K., B. G. Fry, G. K. Isbister, S. Kuruppu, J. Lawrence, A. Ian Smith and W. C. Hodgson (2012). Toxinology of venoms from five Australian lesser known elapid snakes. Basic Clin Pharmacol Toxicol 111(4): 268-274.
Grey Snake (Hemiapsis damelii)
This snake is found in southeastern Queensland. A death in a dog has been described following snakebite by this species. Pigmented urine and marked depression were observed in the dog. Tiger snake antivenom was administered at 18 h after the bite but the dog died at 20 h post-bite. This snake must be considered potentially lethal to animals.
A number of other snake species are potentially dangerous to dogs and cats including:
Brown Tree Snake (Boiga irregularis)
False King Brown Snake (Pailsus pailsei)
De Vis’ Banded Snake (Denisonia devisii)
Ornamental snake (Denisonia maculata)
Marsh Snake, Swamp Snake (Hemiapsis signata)
Common Keelback (Tropidionphis mairii)
Golden Crown Snake (Cacophis squamulosus)
Brown Headed Snake (Furina tristis)
Snake venoms contain a diverse range of both toxic and non-toxic substances. Research over the preceding 100 years has defined the most significant toxins but many molecules remain as yet incompletely described. These toxins likely act in a synergistic manner that have evolved in adaptation to available prey species.
Procoagulants
Venom from the brown snakes, tiger snake and taipans contains substances that promote rapid clotting of blood. These enzyme toxins convert clotting precursor molecules into clots, thereby consuming blood clotting factors. This is termed a venom induced consumptive coagulopathy. Procoagulants are are useful to the snake for prey imobilisation (eg rodents) by extensive and rapid formation of pulmonary thrombi leading to death within minutes. In some snake species procoagulants account for 30% of the venom mass.
Pre-synaptic Neurotoxins
These are generally relatively large molecules (10-88 kD) possessing PLA2 enzyme activity that target the pre-synaptic side of the neuromuscular junction leading to lower motor neurone paralysis. Physical damage to the nerve membranes ensues. Tiger snakes (notexin), brown snakes (textilotoxin), red-bellied black (pseudexin) and taipan (taipoxin) all produced venom with pre-synaptic neurotoxins. Recovery from pre-synaptic lower motor neuron paralysis can take many days or weeks.
Post-synaptic Neurotoxins
Many Australian venomous elapid snakes contain post-synaptic neurotoxins in the venom and these are generally low MW (<10 kD) substances. The post-synaptic neurotoxins are relatively fast acting and due to their site of action (acetylcholine receptors) are much more readily reversed by antivenom than pre-synaptic neurotoxins. Venom from the eastern brown snake (P. textilis) contains multiple post-synaptic neurotoxins. Death adder venom contains multiple psot-synaptic neurotoxins.
Haemolysins
Toxins that directly or indirectly damage red blood cell membranes leading to haemolysis are found in many Australian snakes. These include most prominently the black snakes, particularly the red-bellied black snake, copperheads and tiger snake. Whilst haemolysis may occur with envenomation from other snake species such as the brown and taipan it is generally less clinically significant.
Anticoagulants
Venom from some snakes such as the red-bellied black have anticoagulant properties, which are generally less clinically dramatic and severe than procoagulant toxins.
Myotoxins
Toxins that directly damage skeletal and cardiac muscle are found in many Australian snakes. These include the tiger snake, black snakes, taipan. Widespread muscle damage can occur resulting in profound weakness, delayed recovery and potential for untoward cardiac events. The excretion of myoglobin from damaged muscle cells can leading to kindey damage and renal complications.
Cytotoxins
Local tissue damage and destruction is not commonly observed following envenomation from the majority of Australian venomous snakes unlike some viperid snakes in other parts of the world. However bites from the king brown and red-bellied black snake can occasionally result in extensive local tissue necrosis requiring surgical repair. The underlying molecular pathogenesis of the tissue destruction has not been adequately described.
The diagnosis of snakebite in animals may be very obvious in some situations such as an owner observing a snake encounter, the snakebite and rapid development of clinical signs.
However, in some cases the diagnosis of snakebite can be challenging for veterinarians, particularly when presented with a paralysed animal which may require extensive diagnostic testing.
The primary goal of any diagnostic testing should be to guide rapid and specific antivenom administration and appropriate supportive care.
Snake Identification
In many instances the offending snake is either killed by the animal or owner and presented alongside the presumed envenomed animal. Definitive identification of the snake can be quickly made based on knowledge of venomous snake species in the region and dorsal body scale counting.
Click here to find out what snakes are in your area
Snake Venom Detection
A snake venom detection kit (SVDK) originally developed for skin sampling bite sites of humans has been available for over 30 years in Australia. The SVDK was developed to facilitate snake identification through swabbing of bite sites on human skin, where venom concentrations can be extremely high. The use of the SVDK has been extended to urine and blood samples from humans and animals. The manufacturers stated indication is for 'determination of the type of antivenom that may be required'; not the diagnosis of envenomation.
The SVDK is able to determine the venom immunotype present in the sample. It is not able to identify an individual snake species due to extensive cross reactivity within and between Australia elapid venoms. The SVDK has been evaluated in animal serum and urine and found to be reliable. However false negative results are frequently encountered in animals when used on serum, particularly if a number of hours have elapsed since the bite, due to the rapid excretion of venom or generally low initial levels. Urine samples are more reliable in animals, potentially yielding diagnostic results for up to 24 hours post-bite.
Results from the SVDK are extremely useful for guiding accurate diagnosis and appropriate antivenom selection in animals, although negative results do not exclude envenomation.
Click here for more information on the SVDK
Coagulation Tests
Many snakes cause profound loss of blood coagulation and this can be useful to support a diagnosis of snakebite. Coagulopathy generally precedes the onset of neurological signs (brown, tiger and taipan). Activated clotting time provides a useful and simple measure of the clotting cascade. In many cases no clot will form.
Hand-held coagulation meters appear to be less reliable and data is generally lacking on the utility of these devices for snakebite diagnosis and monitoring in animals. Measurement of prothrombin time, activated partial thromboplastin time, fibrin concentration and thromboelastograms are potentially useful depending upon method and appropriate validation studies.
Serum Biochemistry
Gross serum haemolysis may be present with some snakes including black, tiger, copperhead and some browns. Care must be taken with sample collection to avoid red cell trauma and mechanical haemolysis. Myotoxic activity may be detected with elevations of muscle enzymes (CK, AST) and in some cases liver enzymes (ALT). Although these changes are not specific they can support a diagnosis of snakebite, particularly when considerable time has elapsed from the bite. Renal function indicators such as BUN/CRE are useful to monitor for renal damage and hydration status.
Haematology
Snakes such as the red-bellied black have potential to produce red blood cell morphological abnormalities including spherocytosis, which can further support diagnosis. Massive haemolysis may result in an abnormally low packed cell volume. Centrifuged samples can also be extremely valuable for determining presence of gross haemolysis.
Urinalysis
Collection of urine from potentially envenomed animals is very useful for supporting diagnosis. Urine can be subject to venom detection or simple urinalysis. Gross haemoglobinuria or myoglobinuria will cause dark red or brown discolouration. In some animals glucosuria may also be detected. Black snake and tiger snake envenomation frequently results in pigmenturia. Occasional brown snake cases will have marked haematuria.
Differential Diagnosis
There are a number of causes of lower motor neurone paralysis that may need to be considered.
These include tick paralysis (Ixodes holocyclus), tetrodotoxins (blowfish, puffer fish, toad fish), ciguiatera, polyradiculoneuritis (Coon hound paralysis), organophosphate or carbonate intoxication, thromboembolic disease and meningitis/myelitis.
\n
\n
A range of clinical signs may be exhibited by animals bitten by venomous snakes dependent upon the snake species. The following is a general picture of envenomation by tiger and brown snakes.
Pre-paralytic Signs
In some dogs within minutes of lethal envenomation and prior to paralysis the dog may show 'pre-paralytic signs' and but are infrequently observed in cats. Transient collapse, vomiting, lethargy and weakness may occur followed in some cases by apparent recovery only for gradual onset of fatal paralysis. Experimental studies have confirmed the presence of these signs is consistent with the animal receiving a lethal or multi-lethal dose of venom.
Onset Time of Paralysis
The speed at which paralysis develops has been studied experimentally and is related to the dose of venom received. Flaccid paralysis and respiratory failure may be observed within 1 hour following brown snake envenomation in dogs. Sogs appear more sensitive to paralytic effects than cats.
Cats
Clinical signs of snakebite in cats are more varied than dogs. Often cats are presented to veterinarians in a generalised flaccid paralysed state except for the ability to move the tail and vocalise. Signs of envenomation include generalised weakness, hindlimb paresis, depression, ataxia, vomiting, absent pupillary light reflex, mydriasis, tachypnoea, dyspnoea, intermittent weak struggling, depression and disorientation, pharyngeal paralysis, haematuria, coma, and bleeding from the bite wound.
Dogs
An owner may observe pre-paralytic signs and apparent recovery. Signs of envenomation include vomiting, occasionally haematemisis, haematoptysis, severe trembling, salivation, trismus, excitement, weakness, mydriasis, defecation, posterior paresis progressing to a generalised flaccid paralysis, cyanosis and death.

Horses are highly susceptible to Australian elapid snake venom toxins. The effects of various venoms has been documented experimentally, detailed clinical case reports and veterinary practitioner personal experience.
Overall snakebite is relatively poorly described in horses from Australian elapid snakes, although many cases do occur each year.
The snake species most frequently described to envenom horses are the brown (Pseudonaja sp) snakes and tiger snakes (Notechis scutatus).
Typical signs of envenomation in horses include: muscle tremor, restlessness, sweating, attempting to lay down but standing again, wandering around in a compulsive manner, trying to walk to dams, head pressing, salivation, tongue and pharyngeal paralysis, mydriasis, absence of pupillary light reflex, yet menace reflex may still be present.
Sweating and muscle tremors are frequently observered in horses.
Haematuria/haemoglobinuria/myoglobinuria may be present to varying degrees.
Hindquarter paralysis resulting in recumbency and may progress to a generalised flaccid paralysis.
Dyspnoea with progression to respiratory paralysis and death may occur.
Snake venom detection kits appear to only occasionally return positive results in horses, probably due to the horses large volume of distribution resulting in lower circulating venom/urine concentrations. Repeated testing of urine and/or serum samples over time prior to antivenom administration may result in venom being detected.
Serum biochemistry may reveal elevated CK which is particularly evident with tiger snake envenomation.
In a series of 12 cases of brown snake envenomation in horses (Pascoe et al 1975) it was found that early treatment with antivenom was a key factor in horse or foal survival. The authors commented that brown snake envenomation tended to occur within a day or so following heavy rain and feeding horses off the ground further added to the risk. Brown snake envenomation resulted in signs of drowsiness, stiffness, inability to swallow, paralysis of the tongue, sweating respiratory distress and muscle twitching followed by paralysis.
Reference: Pascoe, R. (1975). Brown snake bite in horses in south-eastern Queensland. J S Afr Vet Assoc 46(1): 129-131.
Click here to read more about a case of tiger snake envenomation in a horse
Click here to read a summary of 52 cases of snakebite in Australian horses
Antivenom is the only specific treatment for envenomation and is lifesaving.
Antivenom works by irreversibly binding to free venom, thereby neutralising its toxic action.
Antivenom must be given intravenously to be effective, absorption is fatally slow by the subcutaneous or intramuscular routes.
Antivenom specific to the offending snake - or of the same immunotype - is essential due to the specific nature of venom toxins.
The Padula Serums Tiger-Brown Snake Antivenom 8000 units will be effective against the vast majority of snake species likely to cause clinically significant envenomation of domestic animals in Australia.
Antivenom must be given early in the envenomation process in order to avoid complications from paralysis. Antivenom may not prevent paralysis from developing due to bound venom being internalised and inaccesible at the neuromuscular junction.
The Padula Serums Tiger-Brown Snake Antivenom 8000 units has been developed to contain sufficient neutralising capacity for large brown and tiger snakes which may produce up to 40 mg of venom. Recent published work on milking of venom from captive snakes has revealed much larger mass of venom may be obtained from Queensland origin brown snakes and the previous estimates of 5-10 mg may be exceded by many snakes.
Suspected cases of snakebite by tiger, black or brown snakes should receive an initial dose of one vial of Tiger-Brown Snake Antivenom 8000 units intravenously.
Confirmed cases of brown snake envenomation should receive an initial dose of either one vial of Tiger-Brown Snake Antivenom 8000 units or one vial of Brown Snake Antivenom 2000 units intravenously.
Further doses of antivenom may be required based on clinical experience and if signs of envenomation are not effectively treated following the initial dose.
Adverse reactions to the highly purified Padula Serums Tiger-Brown Snake Antivenom 8000 units or Brown Snake Antivenom 2000 units are uncommon (<5%) and generally mild. Typical adverse reaction is angioedema resulting in swelling of the face, lips, and eyelids. In most cases this will subside with injectable antihistamine and a steroidal anti-inflammatory.
It is recommended to administer antivenom intravenously in a diluted form (0.9% saline) over approximately 15 minutes to the minimise potential for acute adverse reactions; however in extreme cases, rapid bolus administration may be more appropriate.
Mechanical ventilation (MV) is an essential treatment to ensure survival in snakebitten animals that are exhibiting signs of ventilatory failure.
In severely envenomed animals, unless ventilation is supported death may still occur - despite antivenom - due to the irreversible action of bound venom resulting in profound respiratory muscle paralysis and weakness.
A small percentage of envenomed animals will require lifesaving MV.
Failure to implement MV in a ventilatory compromised animal is likely to lead to death or euthanasia.
The indications for initiating MV with snakebite cases are:
(i) Severe hypoxaemia (SpO2 <90%) despite oxygen; or
(ii) Severe hypoventilation (PCO2 >60 mm/Hg); or
(iii) Unsustainable respiratory effort.
Private veterinary practitioners without access to MV facilities should consider referral to a centre that has appropriate expertise and equipment to perform MV.
First and foremost, an adequate and patent airway must be established. Following rapid sedation, hand ventilation with an Ambu bag connected to an oxygen source can be administered.
An anaesthesia ventilator can be temporarily used (eg, for up to 8 hours) to provide positive pressure ventilation. However, because of the potential for oxygen toxicity from delivery of 100% fraction of inspired oxygen by the anesthesia ventilator, the use of an ICU ventilator is more suitable if longer ventilation is necessary.
To effectively ventilate neurologically intact animals appropriate anaesthesia must be maintained.
Read more: Basics of mechanical ventilation for dogs and cats. Hopper & Powell 2013
In a series of 16 brown snake envenomed cases in Qld, 3/16 received MV for 1-30 hours and all survived (Padula & Leister, 2017).
A potential complication of respiratory paralysis and MV is aspiration pneumonia or other respiratory infection.

Snakebite may result in generalised paralysis and careful pro-active hospital management to minimise potential complications is required.
Significant complications of paralysis include hypoventilation, respiratory arrest, aspiration pneumonia, pulmonary atelectasis, ileus, urine retention, urinary tract infections, decubital ulcers, corneal ulceration and peripheral edema.
It is important to monitor for and implement treatment protocols to prevent or minimize the severity of these complications in snake envenomed animals.
An indwelling urinary catheter may be required to manage a paralysed bladder.
Eye lubrication or other ocular protection is necessary to minimse exposure keratitis.
Tube feeding to ensure adequate nutrition and support recovery.
Pressure sores can be a problem and frequent repositioning is necessary during hospitalisation.
Hospitalised animals should be kept clean and dry to avoid skin issues.
Antivenom alone is not the sole treatment for snakebite.
Hospitalisation and treatment in quiet and low stress environment is recommended.
Intravenous fluid therapy is important to maintain hydration and promote renal blood flow. Hartmann' solution given intravenously at maintenance rates is appropriate.
Broad spectrum antibiotics (eg amoxycillin & clavulanic acid) may be indicated if there is any sign of swelling at the local bite site or if respiration and swallowing is compromised.
Supplementary oxygen may be required in animals that are hypoxic.
Pain may be significant and analgesia required in some cases.
Plasma transfusion is a controversial topic. Many Australian snakes (brown, tiger, taipan) contain procoagulant toxins that rapidly cause a venom induced consumptive coagulopathy. The benefit of a plasma transfusion is that it restores coagulation parameters back to within normal ranges much faster than awaiting spontaneous recovery via hepatic synthesis. Prior antivenom is essential though to neutralise any circulating procoagulant toxins. A downside is the potential for adverse reaction to the transfused plasma and need for close monitoring of total fluid balance. The benefits and risks to plasma transfusion need to be carefully assessed for individual envenomed patients.

There is no doubt many snakebitten animals may die or be found dead before ever being presented to a veterinarian.
Survival rates of cats and dogs promptly presented to a veterinarian, treated appropriately with antivenom, and given supportive care (including mechanical ventilation) have been consistently reported as greater than 90%.
The use of mechanical ventilation vastly improves survival rates in the proportion of cases where it is indicated. Failure to promptly implement mechanial ventilation when spontaneous ventilation is failing results in high death rates and/or frequent compassionate euthanasia.
Long term sequelae appear to be minimal for dogs and cats surviving envenomation.
Occasional cases of red-bellied black snakebite may experience clinically significant anemia (PCV <18%) requiring blood transfusion within a 1-5 days of envenomation. Signs of poor recovery with vomiting and inappatence may be observed, haematological examination is generally diagnostic. The presence of spherocytes is frequently observed resulting from red-bellied black snake venom induced red cell morphological changes. This is likely due to the profound direct haemolytic effects of this venom and irreversible binding to red cell membranes. Monitoring of packed cell volume is advised during recovery.
Any illness following treatment for snake envenomation should be appropriately investigated.
The risk of snakebite can be reduced in animals with careful management and an understanding how animals become envenomed.
Maintain your dog on a lead when walking, dogs running loose are at risk of encountering a snake and being bitten.
Avoid letting dogs run loose into deep vegatation along waterways - snakes love these locations.
Many Australian snakes can swim and snakebite may also occur in or even under the water.
Keep the grass short around your property and remove rubbish piles to reduce snake hiding places.
Snake avoidance training for dogs is offered by some dog trainers and may be useful.
Control of rodents and other potential feed sources for snakes is important. Start by minimising and feed sources for rodents.
Snake-proof fencing and other solid barriers, if well designed, can be used to prevent entry of snakes into dog yards.
Research has been undertaken in the past to try and vaccinate dogs (and humans) against various snake venoms, however this had not led to any commercial vaccines. Toxicity of native venoms and injection site reactions have been problems as well as maintenance of long term immunity.
Drying firewood heaps often harbour snakes and these can pose a risk to both animals and humans.
Take care when burning heaps of old trees, branches and rubbish; snakes may be found in the heap and attempt to escape when the fire starts; dogs may chase and get bitten.
Various snake repellant devices have been marketed to pet owners and manufacturers often seek endorsement via the selling of these products from veterinary clinics. The evidence supporting the efficacy of these devices for reliable repelling of snakes is weak, although they are appealing and often low price. Most expert reptile handlers and researchers are highly skeptical of the efficacy of these devices. Further research is required to objectively document the effects these devices may have as snake deterrents to bolster current anecdotal reports.
Cats are voracious hunters and will readily catch venomous snakes. Housing cats indoors and within enclosures will limit their exposure to potentially lethal snakes.
Many owners report losing working dogs regularly to snakebite in farm and rural situations, particularly to brown snakes. Dogs may be bitten in kennels. Manage these areas carefully (see above) to reduce snake risk.
Effective first aid is generally not possible in most cases of snakebite in animals as most bites occur on the head or trunk. Obvious bites to lower limbs may be amenable to first aid with pressure bandage immobilisation similar to what is recommended for human snakebite.
Due to the expense of treating snakebitten animals by veterinarians, owners should strongly consider pet insurance to reduce the need to make financial based decisions (such as mechanical ventilation) during treatment.
Speak to your regular veterinarian for advice on emergency services they can provide for snakebite.